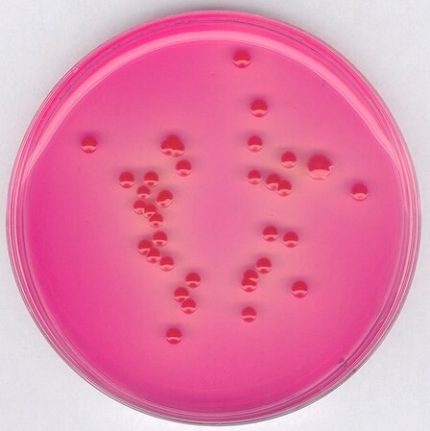
محیط کشت رز بنگال آگار, خرید محیط کشت رز بنگال آگار, Rose Bengal Chloramphenicol Agar, 100467

محیط کشت بلاد آگار | ۱۱۰۸۸۶
فروش محیط کشت بلاد آگار (به انگلیسی: Blood Agar) با کد مرک 110886 اصل و با کیفیتی تضمینی از برند مرک و سیگما آلدریچ توسط آرمان کیمیا زیست، تامین کننده مواد شیمیایی آزمایشگاهی با بیش از ۳۰ سال سابقه
جهت خرید محیط کشت بلاد آگار یا استعلام قیمت آن با ما تماس بگیرید و یا شماره تماس خود را وارد نمائید تا کارشناسان فروش در اسرع وقت با شما تماس بگیرند
محیط کشت بلاد آگار
محیط کشت بلاد آگار (Blood Agar) با کد مرک ۱۱۰۸۸۶ یک محیط کشت غنی است که به طور گستردهای در آزمایشگاههای میکروبیولوژی برای کشت و شناسایی باکتریها بهویژه باکتریهای همولیتیک استفاده میشود.
این محیط کشت شامل آگار و خون گوسفند یا خرگوش است که به عنوان منبع غنی از مواد غذایی و عوامل رشد عمل میکند.
بلاد آگار به دلیل داشتن خون، قادر به تشخیص انواع همولیز (آلفا، بتا و گاما) توسط باکتریها است که این ویژگی در تشخیص و شناسایی گونههای مختلف باکتریایی بسیار مفید است.
اطلاعات فیزیکوشیمیایی:
-
ترکیبات:
- آگار: به عنوان پایه ژلاتینی محیط.
- خون گوسفند یا خرگوش (۵%): منبع غنی از مواد غذایی و عوامل رشد.
-
شکل ظاهری:
- به صورت پودر قهوهای مایل به قرمز است که پس از حل شدن در آب و استریل شدن، به رنگ قرمز روشن درمیآید.
-
pH:
- pH محیط کشت معمولاً در محدوده ۷.۳ ± ۰.۲ تنظیم میشود.
-
دمای نگهداری:
- محیط کشت باید در دمای ۲-۸ درجه سانتیگراد نگهداری شود.
کاربردها:
-
کشت و شناسایی باکتریها:
- محیط کشت بلاد آگار برای کشت انواع باکتریهای گرم مثبت و گرم منفی استفاده میشود.
- به دلیل داشتن خون، این محیط کشت به ویژه برای شناسایی باکتریهای همولیتیک (مانند استرپتوکوکها) بسیار مناسب است.
-
تشخیص همولیز:
- این محیط کشت قادر به تشخیص انواع همولیز (آلفا، بتا و گاما) توسط باکتریها است که در شناسایی و تمایز گونههای مختلف بسیار مهم است.
حجمها:
در حجمهای مختلفی عرضه میشود که شامل بستههای ۵۰۰ گرمی و ۵ کیلوگرمی است. این تنوع در بستهبندی به کاربران امکان میدهد بسته به نیاز آزمایشگاه خود، حجم مناسب را انتخاب کنند.
نحوه استفاده:
- مقدار مشخصی از پودر محیط کشت را با آب مقطر مخلوط کنید.
- مخلوط را به طور کامل هم بزنید تا پودر به طور کامل حل شود.
- محلول را استریل کرده و سپس خون را به آن اضافه کنید.
- محیط کشت آماده شده را در پلیتهای استریل بریزید و در دمای مناسب نگهداری کنید.
خلاصه
یک ابزار اساسی و حیاتی برای کشت و شناسایی باکتریها در آزمایشگاههای میکروبیولوژی است. این محیط کشت با ترکیب ویژهای از آگار و خون، امکانات گستردهای را برای تشخیص انواع باکتریهای همولیتیک فراهم میکند. با توجه به تنوع در بستهبندی و حجمهای مختلف، این محصول میتواند نیازهای مختلف آزمایشگاهی را به خوبی پوشش دهد. برای خرید و کسب اطلاعات بیشتر، میتوانید با کارشناسان ما تماس بگیرید و از مشاوره تخصصی بهرهمند شوید.

محسن –
آیا محصول برای استفاده در آزمایشگاههای آموزشی هم مناسب هست؟